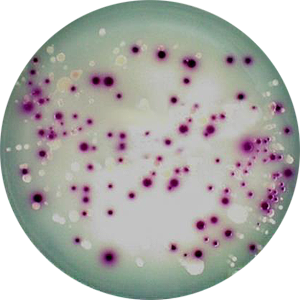

WORLD FIRST: 100 % scalable EliSpot Reader EAZYREADER® 7000
BIOSYS USA applications
Our BIOSYS products
are the right choice for many applications in the laboratory field!
From Elispot to transfection. Our laboratory devices analyze reliably and sustainably. Over 300 satisfied customers worldwide confirm the high efficiency of our devices.
BIOSYS applications
It's your choice of prefered applications - We will show you Bioreader®, EazyReader® and Biocount® models that best matches your requirements!

Elispot

Fluorospot

Live/dead/apoptotic cells

Cell Infection Assay

SARS-CoV-2

Transfection

MCMV and HCMV assay

HEK 293 assay

NK92 cells

Mouse spleen cells

Foci assay

Plaque assays, TCID50, stained

Neutralisation assay

Marek's disease virus Plaques

Organoids

Transgen assay
Colony counting

Antibiotic potency

Adenovirus








